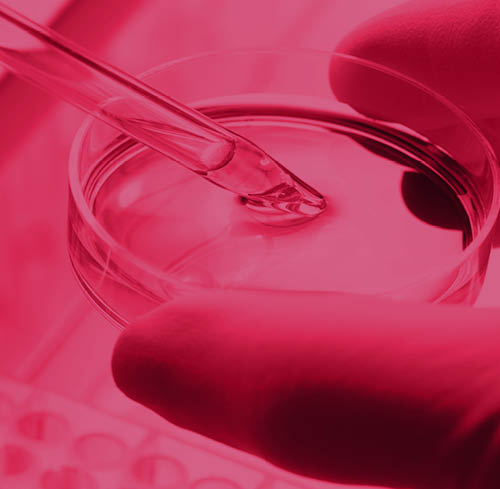

Printing
expertise
for exceptional
results
Printing
expertise
for exceptional
results
Integrated
digital marketing
technologies
Superb
service and
program
management
Responsive
direct mail
campaigns
Precise
packaging
and fulfillment
Rich industry
insight and
experience
You can count on us for the agility and innovation of a digital marketing technology firm, the real-world knowledge that comes with 30 years of direct response, print, and direct mail marketing, and the passion for quality, service, and results that drives everything we do. Learn more.

At Spire, we add the value of deep industry expertise to every project.
Deliver complex omni-channel pharmaceutical marketing campaigns and easy-access, compliant marketing and sales material with best-practice security.
Learn More
Great automotive marketing reaches the right customer with the right offer at the right time, with the ease of custom self-service management tools.
Learn More
Create long-term, one-to-one relationships with prospective students, alumni, and donors with higher education marketing that drives improved responses and revenue.
Learn More
From retirement readiness to financial wellness, we build personalized, compliant financial services marketing communications across all media.
Learn More
Our healthcare marketing connects you to patients, providers, and sales teams, handling complex data that�s secure and HIPAA-compliant.
Learn More
Engage your internal audiences with personalized, effective, data-driven, and compliant Human Resources Employee Communications.
Learn More
From global providers to individual agents, we provide insurance marketing services including full-service acquisition, renewal, and policyholder programs.
Learn More
Luxury is personal. We build one-to-one relationships into our luxury brand marketing campaigns for high-end brands with a focus on quality, consistency, and exceptional service.
Learn More
Showcase properties quickly and easily, and ease in-house creative and administrative resources with streamlined, efficient workflow with our real estate marketing programs.
Learn More
Targeted digital and print retail marketing campaigns to drive traffic, customer engagement, and acquisition with higher response and improved ROI.
Learn More